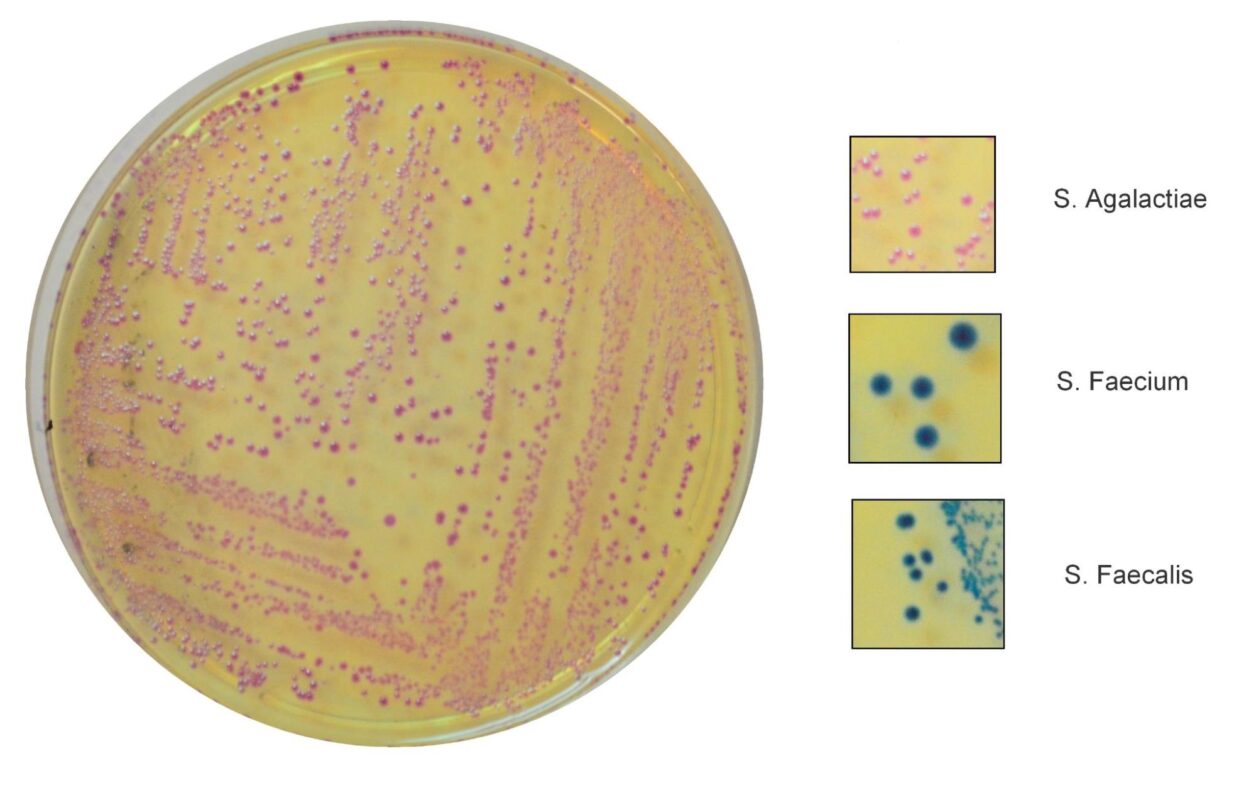
Diagnosi dell’Infezione da Streptococco SGB in Gravidanza

Data la mia lunga esperienza in ospedale come ginecologo ritengo essenziale informarti sulla rilevanza dell’infezione da Streptococco in gravidanza e su come può influire sulla salute del tuo neonato. Questo batterio, Streptococcus agalactiae, è conosciuto anche come streptococco beta-emolitico del gruppo B o più semplicemente Streptococco del Gruppo B (SGB) ed è un ospite naturale del tratto intestinale e vaginale, quindi generalmente è innocuo.
Lo Streptococco in gravidanza, però, potrebbe causare danni al tuo bambino perché può trasformarsi da ospite innocuo ad agente patogeno. Secondo un recente studio negli USA circa il 10-30% delle donne in età fertile sono positive allo SGB e circa il 50-70% dei loro neonati risultano colonizzati dal batterio, di questi l’1-2% sviluppa malattie entro la prima settimana di vita che possono anche portare al decesso se non curate in tempo (Linee Guida Centre for Disease Control CDC, Atlanta, USA, 2010).
La mancanza di sintomi fisici rende il batterio SGB particolarmente insidioso, poiché molte donne non sono consapevoli di esserne portatrici.
Il pericolo principale dello SGB si manifesta durante il travaglio e il parto: il neonato, passando attraverso il canale del parto, può entrare in contatto con il batterio se presente nel canale vaginale e infettarsi. Il sistema immunitario di un neonato, ancora in fase di sviluppo, non è completamente attrezzato per combattere le infezioni, rendendo il bambino vulnerabile a complicazioni potenzialmente gravi.
Questo batterio è responsabile di forme gravi di infezioni durante la prima settimana di vita del neonato: può causare danni cerebrali, paralisi cerebrale infantile, meningite, sepsi, polmonite e, in alcuni casi, la perdita dell’udito o della vista.
Argomenti Trattati
- Infezione da Streptococco del Gruppo B
- Fattori di Rischio dell’Infezione da Streptococco in Gravidanza
- Prevenzione dell’Infezione da Streptococco: Gestione del Neonato
- Diagnosi dell’Infezione da Streptococco SGB in Gravidanza
- Segni e Sintomi dell’Infezione da Streptococco del Gruppo B in Gravidanza
- Trattamento dell’Infezione da Streptococco del Gruppo B in Gravidanza
- FAQ Streptococco del Gruppo B e Danni al Neonato
- Conclusioni
1. Infezione da Streptococco del Gruppo B
Lo SGB è una componente naturale della flora batterica umana e si trova comunemente nel tratto intestinale e genitale di molte donne, anche se molte non ne sono consapevoli a causa della mancanza di sintomi, per questo motivo l’identificazione è molto difficile senza essere sottoposti a test specifici.
La modalità di trasmissione più conosciuta dello Streptococco di gruppo B è quella che avviene dalla madre al neonato, quando durante il parto le secrezioni vaginali vengono a contatto con il bambino nel passaggio attraverso il canale del parto; questo è il momento in cui il bambino è più esposto al rischio di contrarre l’infezione.
Non si conosce, invece, con certezza la modalità di trasmissione del batterio da adulto ad adulto, anche se probabilmente la causa è legata a rapporti sessuali non protetti; lo SGB può infatti colonizzare l’uretra nell’uomo e la mucosa genitale nella donna.
Mentre normalmente non provoca sintomi e non necessita di alcun trattamento antibiotico, lo Streptococco in gravidanza è particolarmente rischioso perché la probabilità di trasmissione da madre a neonato è elevata.
Nel paragrafo precedente abbiamo visto come durante un parto vaginale in presenza di un’infezione da SGB nella madre, oltre la metà dei neonati può contrarre l’infezione. Questo dato può spaventare, ma evidenzia l’importanza dello screening prenatale grazie al quale l’incidenza dell’infezione ad insorgenza precoce si è ridotta dell’80% dal 1990 ad oggi (CDC, 2010).
L’infezione da SGB può manifestarsi in vari modi.
- Nelle donne incinte:
-può essere asintomatica, ovvero senza alcun sintomo evidente;
-può causare infezioni delle vie urinarie, corioamnionite (infezione della membrana che circonda il feto), o parto prematuro;
- Se trasmesso al neonato durante il parto:
-può causare malattie gravi, come la sepsi, la polmonite e la meningite.
La presenza dello Streptococco in gravidanza non è prevedibile e non è collegata a una specifica fase della gestazione. Ciò significa che una donna può essere colonizzata da SGB in qualsiasi momento durante la gravidanza, indipendentemente dal trimestre in cui si trova.
Inoltre, la presenza dello Streptococco può variare nel tempo. Una donna può risultare positiva allo Streptococco in un momento ed essere negativa in un altro. Questo fenomeno è definito come colonizzazione intermittente. In altri casi si può verificare una colonizzazione transitoria, ovvero lo SGB può essere presente per un breve periodo e poi scomparire senza trattamento.
Per questo motivo le Linee Guida per la prevenzione della trasmissione dello Streptococco in Gravidanza sono state revisionate più volte nel tempo perché, alla luce dei numerosi studi effettuati nel corso degli anni, si è giunti alla conclusione che fare un tampone troppo presto non ha alcuna utilità clinica e si è passati da 31-36 a 35-37 settimane di gestazione per identificare la presenza dello Streptococco in gravidanza (CDC, 2010). Nel 2017 le Linee Guida hanno subito una nuova modifica: per prevenire una possibile trasmissione dello Streptococco responsabile dell’insorgenza precoce dell’infezione severa nei neonati, il Royal College of Obstetricians and Gynaecologists ha stabilito che dovranno essere somministrati gli antibiotici a tutte le donne in travaglio prima della 37ma settimana di gravidanza. Questo perché i nati prematuri hanno maggiore probabilità di sviluppare infezioni gravi da GBS rispetto ai neonati a termine: tanto più il bambino nasce prima del termine, tanto più il suo sistema immunitario sarà immaturo, pertanto più elevato sarà il rischio di contrarre forme gravi dell’infezione.
A causa di queste caratteristiche, il ruolo del professionista che ti segue durante la gravidanza è duplice: da un lato, prevenire la trasmissione dell’infezione durante il parto e, dall’altro, garantire un trattamento tempestivo ed efficace del neonato in caso di esposizione al batterio.
Per minimizzare il rischio di trasmissione dello SGB da madre a figlio durante il parto, le raccomandazioni prevedono:
1) un tampone vaginale e rettale in tutte le donne tra 35-37 settimane di gestazione in questo modo si identifica la presenza dello Streptococco in gravidanza.
2) Se il test risulta positivo, la somministrazione di antibiotici durante il travaglio è la strategia più efficace per proteggere il bambino.
La Profilassi Antibiotica Intrapartum ha ridotto in modo drastico la possibilità che l’infezione venga trasmessa dalla madre al neonato e di conseguenza anche il numero di infezioni neonatali della prima settimana di vita.
L’infezione da Streptococco, però, può manifestarsi nel neonato anche successivamente alla prima settimana, si parla di insorgenza tardiva dell’infezione. In questi casi purtroppo gli antibiotici somministrati come profilassi durante il parto non hanno alcun effetto. Nella metà dei casi l’infezione viene trasmessa dalla madre durante il parto solo che si manifesta in modo tardivo nel neonato. Negli altri casi i batteri possono provenire da una contaminazione ambientale: per esempio da altri bambini, da altri membri della famiglia asintomatici o addirittura dagli operatori sanitari con cui il bambino è venuto a contatto.
In rari casi, lo SGB può evolvere in un’infezione più seria anche nella madre, provocando infezioni delle vie urinarie, amnioniti, endometriti, e a volte causare la setticemia.
In alcuni rari casi, lo SGB può essere trasmesso al feto anche durante la gravidanza, attraverso il contatto diretto con il batterio nell’utero:
- Trasmissione Ascendente: Il batterio può risalire dal tratto genitale della madre attraverso le membrane protettive che circondano il feto (amnios e corion), anche se queste non sono ancora rotte. Questo può accadere se le membrane intorno al feto si infettano, condizione nota come corioamnionite.
- Rottura Prematura delle Membrane (PROM): Se le membrane che circondano il feto si rompono prematuramente, può esserci una via di accesso per il batterio per entrare nell’ambiente sterile in cui si trova il feto.
- Trasmissione Ematogena: Anche se meno comune, il batterio può entrare nel flusso sanguigno della madre e attraversare la placenta, infettando così il feto.
2. Fattori di Rischio dell’Infezione da Streptococco in Gravidanza
L’identificazione delle donne con Streptococco del Gruppo B in Gravidanza deve essere eseguita attraverso lo screening batteriologico tramite un test vaginale e rettale da fare tra la 35ma e la 37ma settimana di gestazione. In caso di infezione delle vie urinarie da SGB lo screening batteriologico non è necessario perché la gestante verrà sicuramente sottoposta a Profilassi Antibiotica Intrapartum e ad un trattamento specifico per curare l’infezione del tratto urinario.
I fattori di rischio clinici e anamnestici per l’infezione da Streptococco del Gruppo B nella madre e nel neonato includono vari elementi della storia medica della madre e delle circostanze cliniche che possono aumentare il rischio di trasmissione del batterio dal momento del travaglio fino al parto. Ecco alcuni dei principali fattori di rischio che, a mio avviso, devi conoscere:
- Parto Pretermine: Se le tue membrane si rompono prima della 37ma settimana di gestazione, aumenta significativamente il rischio di trasmissione dello SGB al neonato. Questo accade perché i meccanismi di difesa del neonato potrebbero non essere completamente sviluppati.
- Rottura Prolungata delle Membrane: Un altro fattore di rischio importante è la rottura delle membrane per più di 18 ore prima del parto. Questo prolungato periodo aumenta la probabilità che il neonato entri in contatto con il batterio SGB presente nel canale del parto.
- Infezione del Tratto Urinario Durante la Gravidanza: Se hai avuto un’infezione del tratto urinario, batteriuria, con presenza di SGB durante la gravidanza, questo può indicare la presenza del batterio nel tuo corpo, aumentando il rischio di trasmissione durante il parto.
- Storia Precedente di Neonato con Infezione da SGB: Se in una gravidanza precedente hai partorito un bambino con infezione da SGB, questo indica un aumentato rischio di trasmissione anche nelle gravidanze successive.
- Febbre Durante il Travaglio: La febbre durante il travaglio può essere un segnale di infezione, inclusa la corioamnionite e l’infezione da SGB. È un campanello d’allarme che richiede attenzione immediata.
- Esame Colturale Positivo: Un esame colturale positivo per lo streptococco del gruppo B tra la 35ma e la 37ma settimana di gestazione è un chiaro indicatore del rischio di trasmissione al neonato. Questo test è fondamentale per pianificare il trattamento appropriato durante il travaglio.
- –Procedure invasive durante la gravidanza: L’esecuzione di procedure invasive, come l’amniocentesi, può potenzialmente introdurre il batterio nell’ambiente sterile dell’utero.
- –Intervallo breve tra le gravidanze: Un periodo di tempo ridotto tra le gravidanze può essere associato a un maggiore rischio di colonizzazione da SGB.
La valutazione dei fattori di rischio insieme allo screening batteriologico ha ridotto enormemente l’insorgenza dell’infezione da Streptococco del Gruppo B nel neonato nella prima settimana di vita (fino al 70%) con la necessità di sottoporre a Profilassi un numero ridotto di gestanti (3-5%). (Fonte AOGOI)
3. Prevenzione dell’Infezione da Streptococco: Gestione del Neonato

È importante sottolineare che, sebbene le donne con infezione da SGB spesso non presentano sintomi evidenti, le conseguenze per i neonati possono essere significative. Nel neonato l’infezione da Streptococco SGB si può manifestare in due modalità:
- Forma Precoce dell’Infezione: Nei casi di infezione a esordio precoce (Early Onset, EOD), la trasmissione avviene per via verticale, ovvero il passaggio del batterio dalla madre al bambino avviene prima o durante il processo del parto. Si manifesta generalmente entro la prima settimana di vita, ma nel 90% dei casi entro le prime 12 ore. La EOD è associata a complicazioni durante il travaglio e nei neonati si manifesta con problemi respiratori da difficoltà lievi a condizioni gravi come la polmonite.
- Forma Tardiva dell’Infezione: L’infezione da SGB a esordio tardivo (Late Onset, LOD), si manifesta solitamente dopo la prima settimana dalla nascita e la metà dei casi è dovuta a trasmissione verticale, con l’infezione che si sviluppa in modo tardivo dopo che il batterio è venuto a contatto col neonato durante il parto. Nei rimanenti casi la trasmissione avviene per via orizzontale, legata cioè all’ambiente: può essere causata da una infezione nosocomiale o trasmessa da portatori sani. Generalmente la LOD non è associata a complicazioni materne e può portare a condizioni più gravi come meningite e sepsi, causando anche danni permanenti al neonato. Queste sono condizioni serie che richiedono attenzione immediata e purtroppo non esiste nessuna strategia di prevenzione, né protocolli applicabili al neonato.
Tra i segni e i sintomi dell’infezione da SGB nei neonati, è importante prestare attenzione a:
- Variazioni della temperatura corporea, inclusa la febbre.
- Difficoltà respiratorie, che possono variare da lievi a gravi, incluso l’apnea, ovvero periodi in cui il bambino non respira.
- Cianosi, che si riferisce a una colorazione blu della pelle e delle mucose, indicando che il neonato potrebbe non ricevere abbastanza ossigeno.
- Convulsioni, un segnale allarmante che richiede attenzione medica immediata.
- Cambiamenti nel tono muscolare, che possono variare da rigidità eccessiva a estrema flaccidità.
- Anomalie del battito cardiaco o della pressione sanguigna, segnali di possibili complicazioni.
- Difficoltà nell’attaccarsi al seno o nella nutrizione, che possono indicare disagio o malessere nel neonato.
- Irritabilità o comportamento ansioso, che possono essere segni di disagio o dolore.
Se noti uno qualsiasi di questi segni nel tuo neonato è essenziale contattare immediatamente il medico. Un trattamento tempestivo può evitare danni al neonato come le complicazioni a lungo termine.
4. Diagnosi dell’Infezione da Streptococco SGB in Gravidanza
Nonostante l’infezione da Streptococco del Gruppo B (S. agalactiae) generalmente non manifesti sintomi evidenti nella madre, essa può avere conseguenze serie per il neonato. Per la diagnosi dell’infezione da Streptococco SGB si procede seguendo questi passaggi:
- Screening di Routine Durante il Terzo Trimestre: Data la natura asintomatica dell’infezione da SGB nelle donne incinte, è pratica comune e altamente raccomandata effettuare uno screening durante il terzo trimestre di gravidanza, precisamente tra la 35ª e la 37ª settimana. Questo esame è essenziale per identificare la presenza del batterio e prevenire la trasmissione al neonato.
- Procedura di Screening: Durante la visita, si esegue un tampone vaginale e rettale. Questa procedura semplice e indolore prevede la raccolta di piccoli campioni di secrezione dalla vagina e dal retto, che verranno poi inviati al laboratorio per l’analisi.
- Interpretazione dei Risultati: In caso di esito positivo, ciò indica che sei portatrice del batterio SGB. Ci sono protocolli efficaci per gestire questa situazione ed evitare danni per il tuo bambino. Una profilassi antibiotica durante il travaglio è il metodo standard per prevenire la trasmissione dell’infezione al neonato.
- Diagnosi Post-Parto: Se hai già partorito e c’è il sospetto di infezione da SGB nel tuo bambino, saranno necessari ulteriori test. In questo caso va intrapresa una sorveglianza clinico-diagnostica sul neonato: potrebbe essere prelevato un campione di sangue o di liquido spinale (liquor) del neonato per confermare l’infezione e garantire un trattamento tempestivo e appropriato al tuo piccolo.
- -Tempi di Risposta: I risultati del test colturale, il metodo standard utilizzato in questi casi, possono richiedere tra le 48 e le 72 ore. È importante avere pazienza e attendere i risultati per un piano di cure mirato, ma il Microbiologo può dare una valutazione preliminare già dopo 24 ore dall’inizio della coltura.
5. Segni e Sintomi dell’Infezione da Streptococco del Gruppo B in Gravidanza
L’infezione da Streptococco del Gruppo B (GBS) può manifestarsi in modi diversi nei neonati e nelle madri. È importante notare che mentre nelle madri l’infezione può spesso essere asintomatica, nei neonati può portare a condizioni più gravi. Ecco una panoramica dei sintomi specifici:
Nei Neonati:
- Infezione Precoce (entro la prima settimana di vita):
- Difficoltà respiratorie, che possono variare da respirazione rapida e superficiale a gravi problemi respiratori.
- Ipotonia (tono muscolare ridotto) o irritabilità.
- Instabilità della temperatura corporea, che può includere sia ipotermia che febbre.
- Alimentazione debole o problemi nell’attaccarsi al seno.
- Colorazione bluastra della pelle o cianosi, indicativa di una scarsa ossigenazione.
- Letargia o inattività.
- Tachicardia (battito cardiaco accelerato) o difficoltà cardiache.
- Eventuali convulsioni.
- Infezione Tardiva (dopo la prima settimana di vita fino a 3 mesi):
- Febbre.
- Irritabilità o pianto continuo.
- Difficoltà nell’alimentazione o rigurgito.
- Rigidità del corpo o movimenti anomali.
- Difficoltà respiratorie.
- Gonfiore o rossore intorno al cordone ombelicale.
- Meningite, che può presentarsi con rigidezza del collo, sensibilità alla luce e irritabilità.
Nelle Madri:
- Spesso asintomatica; molte donne portatrici di GBS non mostrano sintomi evidenti.
- In alcuni casi, può causare infezioni delle vie urinarie, che possono presentarsi con sintomi come bruciore durante la minzione, urgenza o frequenza urinaria aumentata, dolore sopra il pube, e a volte febbre.
- Nel caso di infezioni più gravi, come la corioamnionite (infezione delle membrane e dei fluidi intorno al feto), le donne possono sperimentare febbre alta, dolore addominale, contrazioni uterine e secrezioni vaginali maleodoranti.
È importante sottolineare che, in caso di sospetta infezione da GBS sia nel neonato che nella madre, è essenziale consultare immediatamente un medico per una diagnosi accurata e un trattamento tempestivo. La prevenzione attraverso lo screening prenatale e, se necessario, la profilassi antibiotica durante il parto può ridurre significativamente il rischio di trasmissione del GBS dal momento del travaglio fino al parto.
6. Trattamento dell’Infezione da Streptococco del Gruppo B in Gravidanza
La corretta gestione dell’infezione da SGB in gravidanza è essenziale per prevenire complicazioni e danni gravi al neonato come convulsioni, paralisi cerebrale, meningite, sepsi, cecità, ritardi mentali, sordità, disturbi del linguaggio e, nei casi più gravi, anche la morte. Qui di seguito ti illustrerò in modo chiaro e dettagliato come avviene il trattamento dell’infezione da Streptococco del Gruppo B (SGB) durante la gravidanza:
- Tempestività nel Trattamento: Se sei risultata positiva all’infezione da SGB, è fondamentale agire tempestivamente per minimizzare il rischio di trasmissione al neonato.
- Profilassi Antibiotica: La profilassi antibiotica durante il travaglio è il metodo più efficace per prevenire la trasmissione dell’infezione al tuo bambino. La somministrazione di antibiotici è raccomandata in diversi scenari:
- Donne con una storia precedente di neonato affetto da infezione da SGB.
- Donne che presentano il batterio durante la gravidanza, identificato tramite esame delle urine o tampone vaginale.
- Donne con uno stato di infezione sconosciuto che partoriscono prima della 37ma settimana di gestazione, che hanno una febbre durante il parto di 38 gradi o superiore, o in cui si sono rotte le membrane per più di 18 ore prima del parto.
- Antibiotici Raccomandati: La penicillina è l’antibiotico di prima scelta per la profilassi contro lo SGB. È efficace, sicura e ha un basso rischio di effetti collaterali. Per le donne allergiche alla penicillina, l’ampicillina o altri antibiotici alternativi, come la cefazolina, possono essere utilizzati. Gli antibiotici vengono somministrati per via endovenosa (IV) durante il travaglio. Il trattamento dovrebbe iniziare almeno 4 ore prima del parto per garantire una concentrazione efficace dell’antibiotico nel sangue e nel liquido amniotico al momento del parto.
- Monitoraggio del Neonato: Dopo la nascita, il neonato deve essere attentamente monitorato per segni di infezione da SGB. Anche se la madre ha ricevuto la profilassi antibiotica, c’è ancora un piccolo rischio che il neonato possa sviluppare l’infezione.
- I segni di infezione nei neonati possono includere difficoltà respiratorie, letargia, irritabilità, instabilità della temperatura, e problemi di alimentazione. In presenza di questi sintomi, è importante effettuare ulteriori test e iniziare il trattamento antibiotico immediatamente.
- Metodo di Parto e Profilassi Antibiotica: È interessante notare che il metodo di parto, sia esso cesareo o naturale, generalmente non influisce sulla decisione di somministrare la profilassi antibiotica. La priorità rimane proteggere il bambino dall’esposizione all’infezione.
- Ruolo della Terapia Antibiotica: Gli antibiotici somministrati alla madre durante il travaglio eliminano il batterio SGB presente nella vagina, riducendo così il rischio di trasmissione al neonato. Questi antibiotici passano anche attraverso la placenta, fornendo una protezione aggiuntiva al neonato.
- Gestione dei Fattori di Rischio: È importante che il ginecologo monitori attentamente sia la madre che il neonato, soprattutto in presenza di fattori di rischio per l’infezione da SGB. Questo include la valutazione e la gestione del rischio di trasmissione, l’identificazione precoce dei sintomi sia nella madre che nel neonato, e l’intervento tempestivo in caso di segni di infezione.
7. FAQ Streptococco del Gruppo B e Danni al Neonato
- Che cos’è lo Streptococco del Gruppo B?
- Lo Streptococco del Gruppo B (SGB) è un tipo comune di batterio che si trova nel tratto intestinale e vaginale. Nella maggior parte dei casi, non causa problemi nelle donne adulte, ma può essere pericoloso per i neonati se trasmesso durante il parto perché può causare gravi danni al neonato.
- Quando è pericoloso lo Streptococco?
- Le donne incinte sono generalmente sottoposte a screening per GBS tra le 35 e le 37 settimane di gravidanza. Se il risultato del tampone è positivo o se ci sono altri fattori di rischio, viene solitamente raccomandata la profilassi antibiotica durante il travaglio per prevenire la trasmissione del GBS al bambino. Questa profilassi è particolarmente importante se la donna ha avuto un parto pretermine, febbre durante il parto, rottura prematura delle membrane per più di 18 ore, o se GBS è stato trovato nelle urine durante la gravidanza.
- Come si trasmette lo Streptococco del Gruppo B al neonato?
- Nella maggior parte dei casi il neonato contrae l’infezione da SGB durante il passaggio nel canale del parto da una madre infetta. In alcuni rari casi, lo SGB può essere trasmesso al feto prima del parto attraverso il contatto diretto con il batterio nell’utero
- Quali sono i sintomi dell’infezione da SGB nei neonati?
- I sintomi possono includere difficoltà respiratorie, febbre, letargia, irritabilità, difficoltà nell’alimentazione, colorazione bluastra della pelle (cianosi), e in casi più gravi, possono svilupparsi meningite, setticemia e polmonite, fino a causare la morte.
- Come viene diagnosticata l’infezione da SGB?
- Nei neonati, la diagnosi può essere effettuata tramite esami del sangue, del liquido cerebrospinale o di altri fluidi corporei. Nelle donne incinte, lo screening per SGB è di solito fatto tramite un tampone vaginale e rettale tra la 35ª e la 37ª settimana di gravidanza.
- Qual è il trattamento per l’infezione da SGB?
- Nei neonati, il trattamento include tipicamente la somministrazione di antibiotici per via endovenosa. Nelle donne in gravidanza con SGB, la profilassi antibiotica durante il travaglio è il trattamento standard per prevenire la trasmissione al neonato.
- Posso fare qualcosa per prevenire l’infezione da SGB?
- La prevenzione più efficace è lo screening durante la gravidanza e, se positivo, la somministrazione di antibiotici durante il travaglio. Mantenere buone pratiche igieniche e seguire tutte le raccomandazioni del medico durante la gravidanza possono anche aiutare a ridurre i rischi.
- Se sono stata positiva per SGB in una gravidanza precedente, lo sarò anche nelle future gravidanze?
- Non necessariamente. Lo stato di portatore di SGB può cambiare nel tempo, quindi è importante eseguire lo screening per SGB in ogni gravidanza. Se nella gravidanza precedente il tuo bambino è risultato positivo, allora la somministrazione degli antibiotici è fortemente raccomandata.
- Il parto cesareo riduce il rischio di trasmissione di SGB?
- Il parto cesareo può ridurre il rischio di trasmissione di SGB, specialmente se le membrane non si sono rotte o il travaglio non è iniziato. Tuttavia, la decisione di un parto cesareo dovrebbe essere basata su una valutazione complessiva dei rischi e dei benefici.
Si può allattare se sono risultata positiva allo streptococco SGB?
- Sì, le donne che risultano positive al test per Streptococco beta emolitico di Gruppo B possono allattare al seno. Raramente, lo Streptococco beta emolitico di Gruppo B può essere trasmesso ai bambini attraverso il latte materno e i benefici dell’allattamento al seno sono molto maggiori del rischio, davvero molto basso, di diffusione di Streptococco beta emolitico di Gruppo B.
8. Conclusioni
Per ogni futura mamma è fondamentale essere consapevole dell’importanza dello screening per lo Streptococco del Gruppo B (SGB) durante la gravidanza. Come ginecologo, ho visto molti casi in cui un’attenta prevenzione e un trattamento tempestivo hanno fatto la differenza nella salvaguardia della salute del neonato. Ricorda che lo SGB, pur essendo un batterio comunemente innocuo, può trasformarsi in una minaccia seria per il tuo bambino durante il parto, causando meningite, sepsi e polmonite.
L’esempio di Emma, una delle mie pazienti, è illuminante: positiva allo SGB, ha seguito attentamente il nostro piano di profilassi antibiotica durante il travaglio. Il suo bambino è nato sano e senza complicazioni, dimostrando l’efficacia di un intervento tempestivo.
Ti invito, quindi, a non sottovalutare questo aspetto della tua gravidanza. Una semplice analisi tra la 35ª e la 37ª settimana può farti conoscere il tuo stato e permetterci di pianificare il migliore approccio per la sicurezza del tuo bambino.
Se sospetti che il tuo neonato abbia subito danni a causa di un’infezione da Streptococco del Gruppo B non adeguatamente gestita durante il parto, è essenziale agire tempestivamente. In situazioni del genere, dove potrebbe esserci un caso di malasanità, puoi rivolgerti ai legali specializzati di Aiuto Malasanità per tutelare i tuoi diritti e quelli del tuo bambino.
Aiuto Malasanità è composto da professionisti esperti, tra cui avvocati e consulenti medici, che possono fornire assistenza e orientamento nella gestione del tuo caso. Ecco cosa dovresti fare:
- –Documenta tutto: Conserva tutte le registrazioni mediche, i risultati dei test e qualsiasi altra documentazione relativa alla gravidanza, al parto e alle condizioni di salute del neonato. Questi documenti sono fondamentali per valutare il caso.
- Racconta la tua storia: Quando contatti Aiuto Malasanità, sarai invitato a fornire una descrizione dettagliata degli eventi. Sii il più preciso possibile riguardo alle date, ai trattamenti ricevuti e a qualsiasi comunicazione avuta con il personale medico.
- –Valutazione professionale: Gli esperti di Aiuto Malasanità esamineranno il tuo caso per determinare se ci sono stati degli errori nel trattamento o nella diagnosi dell’infezione da Streptococco e se questi hanno causato danni al tuo bambino.
- –Consulenza legale: Se si sospetta un caso di malasanità, ti verrà fornita consulenza legale per comprendere le tue opzioni e i possibili percorsi da intraprendere.
- –Supporto emotivo: Affrontare situazioni di malasanità può essere emotivamente difficile. Aiuto Malasanità può offrire anche supporto emotivo durante questo processo.
Ricorda, ogni situazione è unica e richiede un’attenzione personalizzata. Non esitare a chiedere aiuto e a ottenere il supporto di cui hai bisogno.


